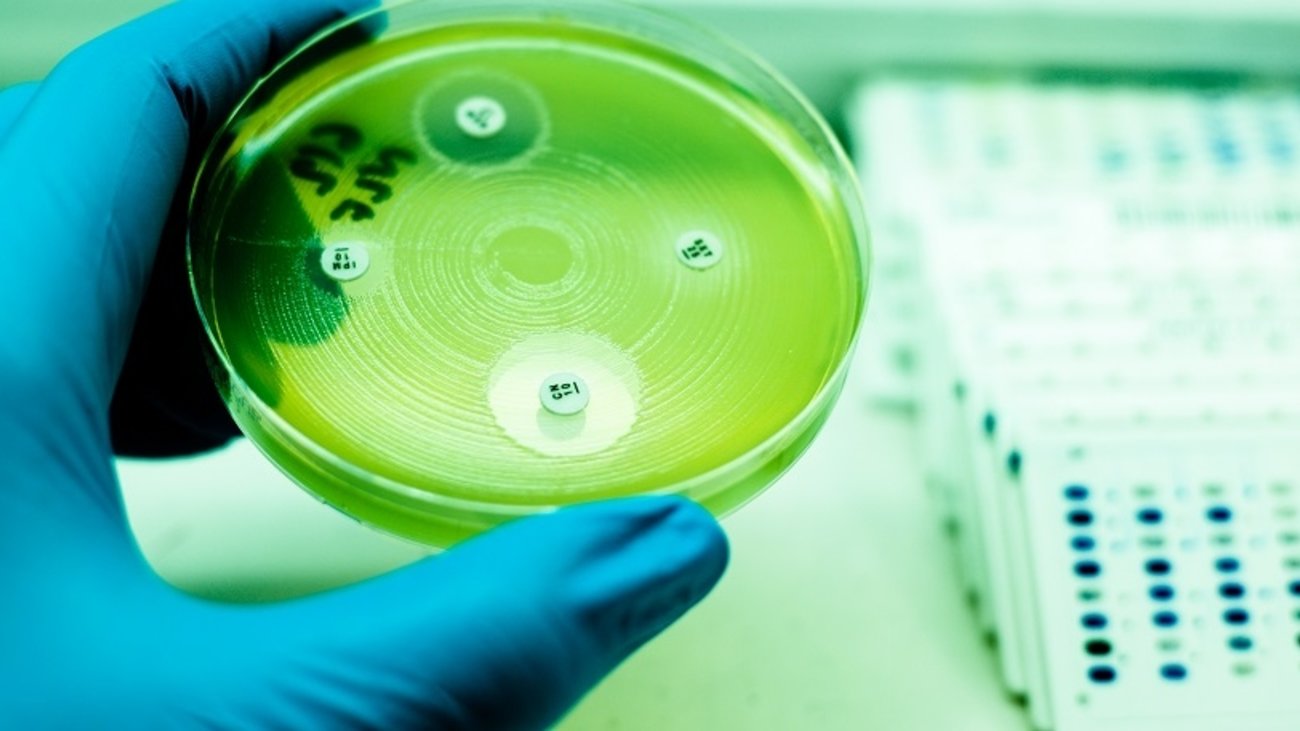
"Γιατρός για Ολους": 12 ερωτήσεις & απαντήσεις για τις αλλαγές που θα φέρει στην καθημερινότητά μας

Ενημέρωση για το νομοσχέδιο που ψηφίζεται σήμερα με 12 ερωτήσεις - απαντήσεις για τις αλλαγές που φέρνει στην καθημερινότητα του πολίτη το σχέδιο Νόμου του Υπουργείου Υγείας με τίτλο "Γιατρός για όλους, Ισότιμη και Ποιοτική Πρόσβαση στις Υπηρεσίες του Εθνικού Οργανισμού Παροχής Υπηρεσιών Υγείας και στην Πρωτοβάθμια Φροντίδα Υγείας και άλλες διατάξεις", κάνει το υπ. Υγείας με ανακοίνωση του.
Αναλυτικά οι 12 ερωτήσεις και απαντήσεις για τον "Γιατρό για Ολους":
1. Τι αλλάζει με τον προσωπικό γιατρό;
Η απουσία, σήμερα, προσωπικών γιατρών οδηγεί τους πολίτες στα νοσοκομεία για απλά ή περίπλοκα προβλήματα υγείας, γεγονός που προκαλεί δυσλειτουργία στο σύστημα και ταλαιπωρία για τους ίδιους. Ο προσωπικός γιατρός θα είναι πλέον εκείνος στον οποίο θα απευθύνονται οι πολίτες και δωρεάν θα συνταγογραφούν φάρμακα, θα παίρνουν οδηγίες, και σε επίπεδο πρόληψης, παραπεμπτικό για εξετάσεις ή για νοσηλεία όταν υπάρχει ανάγκη. Όλες οι υπηρεσίες θα είναι δωρεάν για τους πολίτες.
2. Ποιοι μπορεί να είναι προσωπικοί γιατροί;
Ο προσωπικός γιατρός μπορεί να είναι α) γιατρός Κέντρου Υγείας, Τοπικής Μονάδας Υγείας (Το.Μ.Υ.) ή άλλης δημόσιας δομής ΠΦΥ, β) οικογενειακός γιατρός που παρέχει ήδη τις υπηρεσίες του στο πλαίσιο λειτουργίας των Τοπικών Ομάδων Υγείας όπως προβλέπει ο νόμος 4461/2017, γ) γιατρός συμβεβλημένος με τον ΕΟΠΥΥ, καθώς και ιδιώτης γιατρός. Θα είναι γενικοί γιατροί ή παθολόγοι αλλά δεν αποκλείονται γιατροί άλλων ειδικοτήτων που παρακολουθούν χρονίως πάσχοντες.
3. Ποια θα είναι η διαδικασία επιλογής του προσωπικού γιατρού;
Μόλις δημιουργηθεί το δίκτυο των γιατρών οι πολίτες θα επιλέγουν ελεύθερα, ανάμεσα στους γιατρούς που θα συμμετέχουν ως προσωπικοί ιατροί. Η επιλογή θα γίνεται χωρίς γεωγραφικό περιορισμό. Ο τρόπος εγγραφής θα αποσαφηνιστεί με υπουργική απόφαση αμέσως μετά την ψήφιση του νομοσχεδίου. Η εγγραφή θα γίνεται μέσω εύχρηστης πλατφόρμας και οι πολίτες θα μπορούν να εγγράφονται και μόνοι τους. Οι εγγραφές για τους ανηλίκους θα ξεκινήσει σε μεταγενέστερο στάδιο. Μέχρι τότε οι ανάγκες των βρεφών, παιδιών και εφήβων θα καλύπτονται δωρεάν από τους διαθέσιμους παιδιάτρους των δημόσιων δομών ΠΦΥ και των συμβεβλημένων με τον ΕΟΠΥΥ και με δαπάνη των γονέων από τους ιδιώτες παιδιάτρους.
4. Στους ειδικούς γιατρούς θα είναι δωρεάν η πρόσβαση στον προσωπικό γιατρό;
Με το νέο σύστημα προβλέπεται ότι ως προσωπικοί γιατροί ορίζονται και γιατροί άλλων ειδικοτήτων για τον ενήλικο πληθυσμό, ιδίως όταν η ειδικότητα συνδέεται με παρακολούθηση πολιτών που πάσχουν από χρόνιες ασθένειες. Σε αυτήν την περίπτωση μπορεί οι προσωπικοί γιατροί να είναι και ιδιώτες ειδικοί γιατροί, πχ ένας καρδιοπαθής μπορεί να επιλέξει ως προσωπικό γιατρό τον καρδιολόγο του, ένας ασθενής με χρόνιο αναπνευστικό νόσημα τον πνευμονολόγο του κοκ. Σε κάθε περίπτωση, όταν πρόκειται για ειδικούς γιατρούς συμβεβλημένους με τον ΕΟΠΥΥ η πρόσβαση θα είναι δωρεάν.
5. Είναι υποχρεωτική η εγγραφή στον προσωπικό γιατρό;
Στόχος του υπουργείου Υγείας είναι μέσω του προσωπικού γιατρού να προωθηθεί η αλλαγή κουλτούρας σε θέματα υγείας και οι πολίτες να αναπτύξουν σχέση εμπιστοσύνης με τον γιατρό τους ανάλογη με εκείνη που διατηρούν συνήθως ως γονείς με τους παιδίατρους των παιδιών τους. Συνεπώς δεν γίνεται λόγος για υποχρεωτικότητα εγγραφής. Ωστόσο, διαμορφώνεται ένα πλαίσιο κινήτρων για τους πολίτες ώστε να επιλέγουν την εγγραφή.
6. Στις περιοχές που ενδεχομένως δεν υπάρχουν γιατροί, πού θα εγγράφονται οι πολίτες;
Αν σε κάποια περιοχή δεν υπάρχουν διαθέσιμοι γιατροί, θα μπορούν να επιλέγουν γιατρό από άλλη περιοχή και να τον συμβουλεύονται με τα μέσα της σύγχρονης τεχνολογίας.
7. Πώς θα εξασφαλιστεί η συμμετοχή των γιατρών;
Θα δοθεί κίνητρο οικονομικό στους γιατρούς ώστε να συμμετάσχουν στο δίκτυο των προσωπικών γιατρών και να αναλάβουν πληθυσμό αναφοράς. Όσοι γιατροί δεχθούν τον μέγιστο αριθμό εγγεγραμμένων πολιτών (2.000) θα λάβουν αμοιβή κατ άτομο. Όσο περισσότερους ασθενείς γράφει ο γιατρός τόσο περισσότερα χρήματα θα παίρνει. Οι γιατροί των Κέντρων Υγείας ή των ΤΟΜΥ θα λαμβάνουν επιπλέον αμοιβή.
8. Τι προσδοκά ο πολίτης από τις ρυθμίσεις του ΕΟΠΥΥ σε σχέση με τα κριτήρια ποιότητας της Επιτροπής Διαπραγμάτευσης;
Η εισαγωγή Κριτηρίων Ποιότητας διασφαλίζει καλύτερες υπηρεσίες για τους πολίτες. Ταυτόχρονα όλοι οι Πάροχοι Υγείας θα έχουν κίνητρο ώστε να βελτιώσουν την ποιότητα υπηρεσιών και να αμείβονται καλύτερα από τον ΕΟΠΥΥ. Σε σχέση με την Επιτροπή Διαπραγμάτευσης Τιμών πάλι θα έχει όφελος ο πολίτης γιατί η Επιτροπή Διαπραγμάτευσης θα εξασφαλίζει καλύτερες τιμές για τον ΕΟΠΥΥ και επομένως χαμηλότερο κόστος συμμετοχής για τους ασθενείς.
9. Τι σημαίνει για τον ασθενή η τροποποίηση και η βελτίωση του Ηλεκτρονικού Φακέλου Ασφαλιστικής Δαπάνης;
Η εφαρμογή για τη δημιουργία Ηλεκτρονικού Φακέλου Δαπανών Ασφαλισμένου δικαιούχου είναι σημαντική γιατί δίνει τη δυνατότητα στον ασφαλισμένο στον ΕΟΠΥΥ να έχει άμεση πρόσβαση στις δαπάνες που τον αφορούν. Έτσι περιορίζονται οι δυνατότητες παράτυπων χρεώσεων αλλά και ο ασθενής έχει πλήρη εικόνα των υπηρεσιών που λαμβάνει και του κόστους τους. Να σημειωθεί ότι υπάρχει δυνατότητα αμφισβήτησης από τον ασφαλισμένο σε περίπτωση που δεν έχουν πραγματοποιηθεί ή έχουν υπερκοστολογηθεί, των εξετάσεων που αναγράφονται στον φάκελο του ασφαλισμένου.
10. Ποια η σημασία για την επιτήρηση και τον έλεγχο των λοιμώξεων στις Δημόσιες Μονάδες Παροχής Υπηρεσιών Πρωτοβάθμιας Φροντίδας Υγείας;
Όλοι γνωρίζουμε ότι η Χώρα μας καταγράφει χαμηλές επιδόσεις στον τομέα των λοιμώξεων εντός μονάδων υγείας. Με την έννοια αυτή είναι πολύ σημαντική η θεσμοθετημένη επιτήρηση και ο έλεγχος των λοιμώξεων στις Δημόσιες Μονάδες Πρωτοβάθμιας Φροντίδας Υγείας. Ορίζονται οι υπεύθυνοι επιτήρησης λοιμώξεων και οι μονάδες ΠΦΥ συνδέονται με Νοσοκομεία Αναφοράς για την υποστήριξη των μέτρων επιτήρησης λοιμώξεων. Πρόκειται για μέτρο Δημόσιας Υγείας πολύ σημαντικό που μειώνει τα περιστατικά λοιμώξεων και δίνει μεγαλύτερο αίσθημα ασφάλειας στους πολίτες ειδικά κατά τη διάρκεια της επιδημίας όπου παρατηρείται μεγάλη έξαρση ενδονοσοκομειακών λοιμώξεων καθότι ένα σημαντικό ποσοστό θανάτων, όπως έχει τονιστεί από λοιμωξιολόγους, στους νοσηλευόμενους με Covid-19 οφείλεται στα πολυανθεκτικά μικρόβια, από τα οποία μολύνθηκαν. Είναι σημαντικό να τονίσουμε ότι αναμένεται ραγδαία αύξηση των ενδονοσοκομειακών λοιμώξεων και σύμφωνα με την Επιτροπή Λοιμώξεων του Συστήματος Υγείας της Βρετανίας προβλέπεται ότι το 2050 η πρώτη αιτία θανάτου παγκοσμίως θα είναι οι λοιμώξεις που προκαλούν τα ανθεκτικά μικρόβια.
11. Τι θα ωφεληθούν οι ασθενείς από την θεσμοθέτηση της ανάπτυξης και οργάνωσης της κατ' οίκον νοσηλείας και φροντίδας υγείας σε μονάδες υγείας του Εθνικού Συστήματος Υγείας;
Η νοσηλευτική φροντίδα του ασθενούς στο σπίτι είναι ένα θέμα που αφορά έναν ολοένα αυξανόμενο αριθμό ηλικιωμένων ανθρώπων και ανθρώπων με χρόνιες αλλά και οξείες παθήσεις. Οι ασθενείς μπορούν να αποφεύγουν τις άσκοπες και δαπανηρές εισαγωγές στα νοσοκομεία ή τη μεγάλη αναμονή λόγω αυξημένου φόρτου εργασίας υγειονομικού προσωπικού, στα εξωτερικά ιατρεία προκειμένου να εξεταστούν. Πολύ σημαντικό είναι ότι αποτρέπει τη μεγάλη παραμονή τους στο νοσοκομείο (ιδρυματοποίηση), αποφεύγοντας έτσι τις ενδονοσοκομειακές λοιμώξεις, που αποτελούν ένα ακόμη συχνό πρόβλημα και τα τελευταία χρόνια βρίσκονται σε έξαρση. Η Κατ'οίκον Νοσηλεία και φροντίδα υγείας αναπτύσσεται και οργανώνεται σύμφωνα με τις ανάγκες των πολιτών παρέχοντας σε αυτούς υψηλού επιπέδου υπηρεσίες υγείας. Τέλος, απαλλάσσει από το βάρος φροντίδας των ασθενών αυτών το οικογενειακό περιβάλλον. Επίσης αποδεσμεύει ένα μεγάλο αριθμό κλινών από τα Νοσοκομεία του ΕΣΥ οι οποίες μπορούν να διατεθούν σε ανθρώπους που έχουν άμεση ανάγκη νοσηλείας.
12. Τι σημαίνει η θεσμοθέτηση της Εθνικής Επιτροπής Στοματικής Υγείας;
Το νέο αυτό όργανο για θέματα στοματικής υγείας εισηγείται την Εθνική Στρατηγική για τη Στοματική Υγεία, γνωμοδοτεί για την εκπαίδευση της ειδικότητας και τη συνεχιζόμενη κατάρτιση οδοντιάτρων. Η στοματική υγεία ως αναπόσπαστο τμήμα της δημόσιας υγείας οφείλει να τεθεί σε υψηλή προτεραιότητα και αυτό επιβάλλουν οι ισχνοί δείκτες της Στοματικής Υγείας του Ελληνικού πληθυσμού. Είναι ένα πρώτο σημαντικό βήμα από τα πολλά που πρέπει να γίνουν για τη βελτίωση της Στοματικής Υγείας στη Χώρα μας.
Οι πιο πρόσφατες Ειδήσεις
Διαβάστε πρώτοι τις Ειδήσεις για ό,τι συμβαίνει τώρα στην Ελλάδα και τον Κόσμο στο thetoc.gr